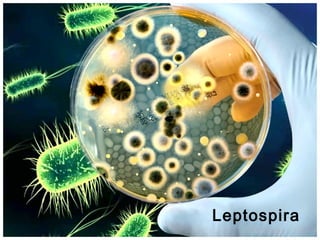
Leptospira
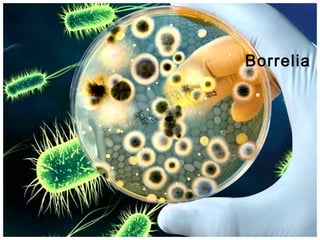
Borrelia

This document summarizes information about the spirochete Treponema pallidum, the causative agent of syphilis. It discusses the morphology, structure, culture, staining, treatment and diagnosis of T. pallidum. It also covers the clinical stages of syphilis including primary, secondary, latent and tertiary syphilis. Laboratory tests for diagnosing syphilis including dark-field microscopy, serological tests like VDRL and FTA-ABS are mentioned. The typical clinical manifestations at each stage of syphilis are briefly described.










![Cardiolipin antigen
• Chemically a diphosphatidyl glycerol
• This lipid has been detected in T.pallidum
• Used as antigen in the standard tests for syphilis
[STS] or nonspecific tests for syphilis
– Wassermann test
– Kahn test
– VDRL test](https://image.slidesharecdn.com/spirochetesallied2003-140215233809-phpapp02/85/Spirochetes-for-undergraduate-students-treponema-leptospira-borrelia-11-320.jpg)










![Tertiary Syphilis
• After the period of latent syphilis
in many
cases
natural cure
• Others manifestations of tertiary syphilis
• CVS
syphilitic aneurysm
• Chronic granulomata
gummata
• Meningo-vascular meningitis
• Neurological
tabes dorsalis and general
paralysis of insane [GPI]](https://image.slidesharecdn.com/spirochetesallied2003-140215233809-phpapp02/85/Spirochetes-for-undergraduate-students-treponema-leptospira-borrelia-22-320.jpg)






![VDRL
• Developed in New york
• Test is done on VDRL slide –
• To the Inactivated serum [heating serum at
550C]taken in dilutions 1 drop of cardiolipin antigen is
added
• Mix well in VDRL rotator [ 180 rpm/4mts ]
• Visible clumps/floccules appear on the slide if the
patient serum contain antibody
• Seen under low power microscope
• Serial dilution to determine Ab titer in positive cases](https://image.slidesharecdn.com/spirochetesallied2003-140215233809-phpapp02/85/Spirochetes-for-undergraduate-students-treponema-leptospira-borrelia-29-320.jpg)